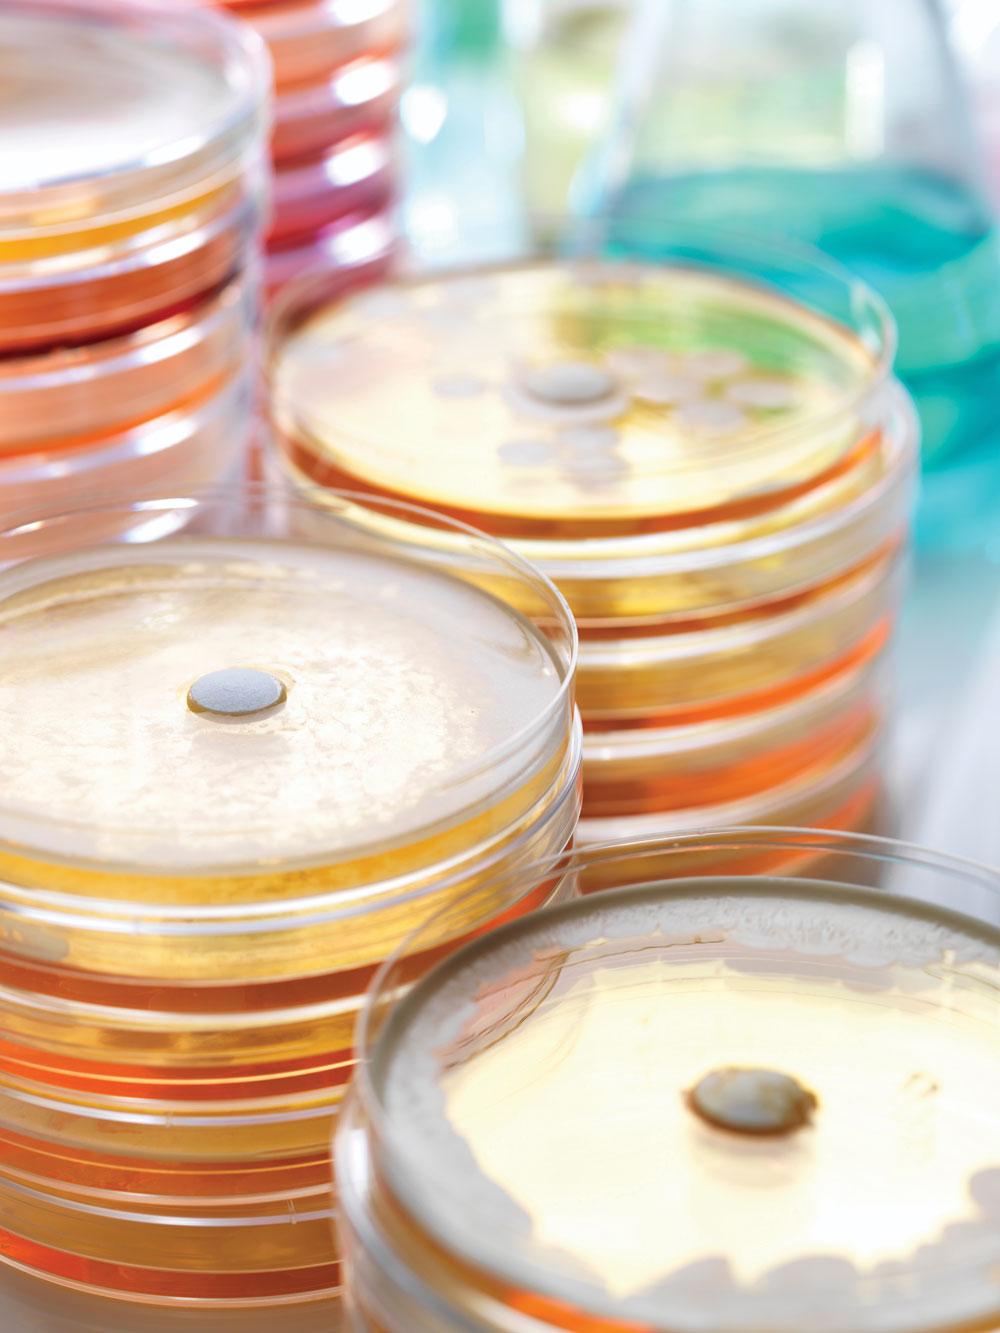

Top ten threats to global health
Mandy Galloway, Editor
Mandy Galloway, Editor
This is a snap shot of ten threats to global health, identified by the World Health Organization: some of these may appear remote, but others have very direct implications for us in the UK
We can get so bogged down in our own problems that it can be easy to lose sight of the bigger picture. But once in a while, it is worth putting aside the pressures we face in UK primary care for a second to look at wider issues.
The world is facing multiple health challenges, ranging from outbreaks of vaccine-preventable diseases like measles and diphtheria, increasing reports of drug-resistant pathogens, growing rates of obesity and physical inactivity to the health impacts of environmental pollution and climate change and multiple humanitarian crises.
To address these and other threats, 2019 sees the start of the World Health Organization’s new 5-year strategic plan. The plan focuses on a triple billion target to ensure:
- 1 billion more people benefit from access to universal health coverage
- 1 billion more people are protected from health emergencies, and
- 1 billion more people enjoy better health and well-being. Reaching this goal will require addressing the threats to health from a variety of angles.
AIR POLLUTION AND CLIMATE CHANGE
Nine out of ten people breathe polluted air every day. In 2019, air pollution is considered by WHO as the greatest environmental risk to health. Microscopic pollutants in the air can penetrate respiratory and circulatory systems, damaging the lungs, heart and brain, killing 7 million people prematurely every year from diseases such as cancer, stroke, heart and lung disease. Around 90% of these deaths are in low- and middle-income countries, with high volumes of emissions from industry, transport and agriculture, as well as dirty cooking stoves and fuels in homes.
The primary cause of air pollution (burning fossil fuels) is also a major contributor to climate change, which impacts people’s health in different ways. Between 2030 and 2050, climate change is expected to cause 250,000 additional deaths per year, from malnutrition, malaria, diarrhoea and heat stress.
The BMA, a founding member of the UK Health Alliance for Climate Change, says it is vital to tackle air pollution and climate change together to protect the ‘most vulnerable in society while also reducing the burden on health services’. The BMA says: ‘Exposure to air pollution, including fine particulate matter and nitrogen dioxide, is associated with a wide range of adverse health impacts – it has been estimated that around 40,000 deaths a year in the UK are attributable to outdoor air pollution. Potential adverse health consequences of climate change include an increase in frequency and severity of extreme weather events such as floods, droughts, extreme storms and heatwaves; the spread of vector-borne diseases such as malaria and dengue to new locations; worsening nutrition resulting from decreased agricultural productivity and higher global food prices; rising sea levels and associated population displacement; and an exacerbation of poverty and inequalities.’
NON-COMMUNICABLE DISEASES
Diseases such as diabetes, cancer and heart disease, account for over 70% of all deaths worldwide, or 41 million people. This includes 15 million people dying prematurely, aged between 30 and 69.
The rise of these diseases has been driven by five major risk factors: tobacco use, physical inactivity, the harmful use of alcohol, unhealthy diets and air pollution. These risk factors also exacerbate mental health issues, that may originate from an early age: half of all mental illness begins by the age of 14, but most cases go undetected and untreated – suicide is the second leading cause of death among 15-19 year-olds.
WHO has set a global target of reducing physical inactivity by 15% by 2030.
In the UK, the NHS Long Term Plan2 sets out proposals to help prevent 150,000 heart attacks, strokes and dementia cases. Among its aims are for more than 3 million people to have access to new and improved stroke, respiratory and cardiac services over the next decade. New, individually tailored treatments for cancer will be introduced alongside cutting edge testing services that will mean three quarters of cancer patients are diagnosed early, when the condition is easier to treat, up from half at present, saving 55,000 lives a year. Around 23,000 premature deaths and 50,000 hospital admissions will be prevented over the next decade by putting over 100,000 patients with heart problems through a healthy living and exercise programme every year. A renewed focus on prevention including action to help people live healthier lives will stop thousands of people developing life threatening or limiting conditions, including the expansion of the Diabetes Prevention Programme.
FLU PANDEMIC
The world will face another influenza pandemic – the only thing we don’t know is when it will hit and how severe it will be. Global defences are only as effective as the weakest link in any country’s health emergency preparedness and response system.
WHO is constantly monitoring the circulation of influenza viruses to detect potential pandemic strains: 153 institutions in 114 countries are involved in global surveillance and response.
Every year, WHO recommends which strains should be included in the flu vaccine to protect people from seasonal flu. In the event that a new flu strain develops pandemic potential, WHO has set up a unique partnership with all the major players to ensure effective and equitable access to diagnostics, vaccines and antiviral drugs, especially in developing countries.
ANTIMICROBIAL RESISTANCE
The development of antibiotics, antivirals and antimalarials are some of modern medicine’s greatest successes. Now, time with these drugs is running out. Antimicrobial resistance – the ability of bacteria, parasites, viruses and fungi to resist these medicines – threatens to send us back to a time when we were unable to easily treat infections such as pneumonia, tuberculosis, gonorrhoea, and salmonellosis. The inability to prevent infections could seriously compromise surgical procedures and treatments such as chemotherapy.
Resistance to tuberculosis drugs is a formidable obstacle to fighting a disease that causes around 10 million people to fall ill, and 1.6 million to die, every year. In 2017, around 600 000 cases of tuberculosis were resistant to rifampicin – the most effective first-line drug – and 82% of these people had multidrug-resistant tuberculosis.
Drug resistance is driven by the overuse of antimicrobials in people, but also in animals, especially those used for food production, as well as in the environment. WHO is working with these sectors to implement a global action plan to tackle antimicrobial resistance by increasing awareness and knowledge, reducing infection, and encouraging prudent use of antimicrobials.
In the UK, Health Secretary Matt Hancock has announced a national action plan to step up the fight against antibiotic resistance, which includes reducing antibiotic use in humans by 15% over the next 5 years, and cutting antibiotic use in animals by 25% from 2016 levels by next year. He said: ‘Each and every one of us benefits from antibiotics but we all too easily take them for granted and I shudder at the thought of a world in which their power is diminished.
‘Antimicrobial resistance is as big a danger to humanity as climate change or warfare. That's why we need an urgent global response.’
RCGP chair Professor Helen Stokes-Lampard said prescribers in primary care were ‘already making excellent headway in reducing antibiotic use in the community and will only prescribe when they are absolutely necessary and the best course of action for the patient sitting in front of us… [but] we need to get to a stage where antibiotics are not seen by patients as a “catch-all” for every illness but as a serious dug option, usually reserved for when all other treatment options have either failed or been deemed inappropriate.’
VACCINE UPTAKE
Vaccine hesitancy – the reluctance or refusal to vaccinate despite the availability of vaccines – threatens to reverse progress made in tackling vaccine-preventable diseases. Vaccination is one of the most cost-effective ways of avoiding disease – it currently prevents 2-3 million deaths a year, and a further 1.5 million could be avoided if global coverage of vaccinations improved.
Measles, for example, has seen a 30% increase in cases globally. The reasons for this rise are complex, and not all of these cases are due to vaccine hesitancy. However, some countries that were close to eliminating the disease have seen a resurgence.
The reasons why people choose not to vaccinate are complex; a vaccines advisory group to WHO identified complacency, inconvenience in accessing vaccines, and lack of confidence are key reasons underlying hesitancy. Health workers, especially those in communities, remain the most trusted advisor and influencer of vaccination decisions, and they must be supported to provide trusted, credible information on vaccines.
In 2019, WHO will ramp up work to eliminate cervical cancer worldwide by increasing coverage of the HPV vaccine, among other interventions. 2019 may also be the year when transmission of wild poliovirus is stopped in Afghanistan and Pakistan. Last year, less than 30 cases were reported in both countries. WHO and partners are committed to supporting these countries to vaccinate every last child to eradicate this crippling disease for good.
In the UK, Public Health England and its counterparts in Scotland, Wales and Northern Ireland have developed a joint strategy to increase uptake of the MMR vaccine, which has declined in recent years, particularly for the second dose. Average uptake across the UK is 88%, well short of the WHO target of 95% needed to achieve population immunity.
PHE says there is a risk that the UK will lose its measles elimination status unless steps are taken to address vaccination ‘gaps’.3
HIV AND AIDS
The progress made against HIV has been enormous in terms of getting people tested, providing them with antiretrovirals (22 million are on treatment), and providing access to preventive measures such as a pre-exposure prophylaxis (PrEP, which is when people at risk of HIV take antiretrovirals to prevent infection).
However, the epidemic continues to rage with nearly a million people every year dying of HIV/AIDS. Since the beginning of the epidemic, more than 70 million people have acquired the infection, and about 35 million people have died. Today, around 37 million worldwide live with HIV. Reaching people like sex workers, people in prison, men who have sex with men, or transgender people is hugely challenging. Often these groups are excluded from health services. A group increasingly affected by HIV are young girls and women (aged 15–24), who are particularly at high risk and account for 1 in 4 HIV infections in sub-Saharan Africa despite being only 10% of the population.
This year, WHO will work with countries to support the introduction of self-testing so that more people living with HIV know their status and can receive treatment (or preventive measures in the case of a negative test result).
WEAK PRIMARY HEALTH CARE
Primary health care is usually the first point of contact people have with their health care system, and ideally should provide comprehensive, affordable, community-based care throughout life.
Primary health care can meet the majority of a person’s health needs of the course of their life. Health systems with strong primary health care are needed to achieve universal health coverage.
Yet many countries do not have adequate primary health care facilities. This neglect may be a lack of resources in low- or middle-income countries, but possibly also a focus in the past few decades on single disease programmes. In October 2018, WHO co-hosted a major global conference in Astana, Kazakhstan at which all countries committed to renew the commitment to primary health care made in the Alma-Ata declaration in 1978.
In 2019, WHO will work with partners to revitalize and strengthen primary health care in countries, and follow up on specific commitments made by in the Astana Declaration.4
In England, the NHS Long Term Plan aims to strengthen primary care by tackling recruitment and retention issues, boosting funding, and increasing digital access for patients to reduce the need for face-to-face contact. ‘Vanguard’ models of integrated care systems will be expanded, and neighbouring GP practices will be encouraged to join forces to create new primary care networks encompassing a wider range of staff, and typically serving populations of 30 – 50,000.2
- See The NHS Long Term Plan: what it means to practice nurses, Practice Nurse January 2019;49(01):8-9
FRAGILE AND VULNERABLE SETTINGS
More than 1.6 billion people (22% of the global population) live in places where protracted crises (through a combination of challenges such as drought, famine, conflict, and population displacement) and weak health services leave them without access to basic care.
Fragile settings exist in almost all regions of the world, and these are where half of the key targets in the sustainable development goals, including on child and maternal health, remains unmet.
WHO will continue to work in these countries to strengthen health systems so that they are better prepared to detect and respond to outbreaks, as well as able to deliver high quality health services, including immunisation.
EBOLA AND HIGH-THREAT DISEASES
In 2018, the Democratic Republic of the Congo saw two separate Ebola outbreaks, both of which spread to cities of more than 1 million people. One of the affected provinces is also in an active conflict zone.
This shows that the context in which an epidemic of a high-threat pathogen like Ebola erupts is critical – what happened in rural outbreaks in the past doesn’t always apply to densely populated urban areas or conflict-affected areas.
At a conference on Preparedness for Public Health Emergencies held last December, participants from the public health, animal health, transport and tourism sectors focussed on the growing challenges of tackling outbreaks and health emergencies in urban areas. They called for WHO and partners to designate 2019 as a ‘Year of action on preparedness for health emergencies’.
WHO’s R&D Blueprint identifies diseases and pathogens that have potential to cause a public health emergency but lack effective treatments and vaccines. This watchlist for priority research and development includes Ebola, several other haemorrhagic fevers, Zika, Nipah, Middle East Respiratory Syndrome coronavirus (MERS-CoV) and Severe Acute Respiratory Syndrome (SARS) and disease X, which represents the need to prepare for an unknown pathogen that could cause a serious epidemic.
DENGUE
Dengue, a mosquito-borne disease that causes flu-like symptoms and can be lethal and kills up to 20% of those with severe dengue, has been a growing threat for decades.
A high number of cases occur in the rainy seasons of countries such as Bangladesh and India. Now, its season in these countries is lengthening significantly (in 2018, Bangladesh saw the highest number of deaths in almost two decades), and the disease is spreading to less tropical and more temperate countries such as Nepal, that have not traditionally seen the disease.
An estimated 40% of the world is at risk of dengue fever, and there are around 390 million infections a year. WHO’s Dengue control strategy aims to reduce deaths by 50% by 2020.
REFERENCES
1. WHO. Ten threats to global health in 2019, 2019 https://www.who.int/emergencies/ten-threats-to-global-health-in-2019
2. NHS England. The NNHS Long Term Plan, 2019. https://www.longtermplan.nhs.uk/wp-content/uploads/2019/01/nhs-long-term-plan.pdf
3. Public Health England, Public Health Wales, Public Health Agency, Health Protection Scotland. UK Measles and Rubella elimination strategy 2019, January 2019. https://assets.publishing.service.gov.uk/government/uploads/system/uploads/attachment_data/file/769970/UK_measles_and_rubella_elimination_strategy.pdf
4. WHO and UNICEF. Declaration of Astana, Global Conference on Primary Health Care, 2018. https://www.who.int/docs/default-source/primary-health/declaration/gcphc-declaration.pdf
Related articles
View all Articles